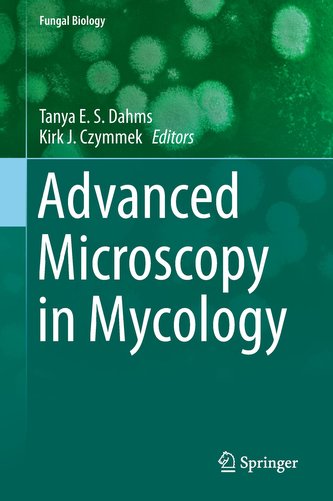

Advanced Microscopy in Mycology
67
%
833 Kč 2 532 Kč
Sleva až 70% u třetiny knih
| Autor: | Dahms, Tanya |
| Nakladatel: | Springer-Verlag GmbH |
| ISBN: | 3319224360 |
| Rok vydání: | 2015 |
| Jazyk : | Angličtina |
| Vazba: | Hardback |
Mohlo by se vám také líbit..
-

Difficulty in Poetry
Castiglione, Davide
-

Personale Medizin
Gerhard Danzer
-

Theoretische Mechanik
Ilk, Karl Heinz
-

Technische Transport- und Lagerlogistik
Martin, Heinrich
-

Einführung in die Ölhydraulik
Matthies, Hans J.
-

Produktdesign
Bühler, Peter
-

Computer Aided Verification
Gopalakrishnan, Ganesh
-

Methoden der Mikrobiologie
Brandis-Heep, Astrid
-

Actuarial Sciences and Quantitative F...
Londoño, Jaime A.
-

Faszination Meeresforschung
Hempel, Gotthilf
-

The Dynamics of Change in Higher Educ...
Kyvik, Svein
-

Geographie
Gebhardt, Hans
-

Correlated Random Systems - Five Diff...
Gayrard, Véronique
-

Orchestrating Human-Centered Design
Boy, Guy Andre (Professor Centralesupelec & Estia)
-

Springer Lexikon Kosmetik und Körperp...
Bährle-Rapp, Marina
-

Sustainable Fashion: Consumer Awarene...
Muthu, Subramanian Senthilkannan